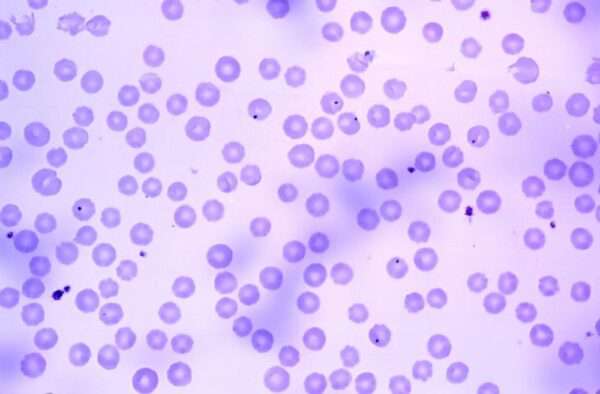
Ehrlichiosis y Anaplasmosis

La ehrlichiosis y la anaplasmosis humanas son enfermedades endémicas en los Estados Unidos debido a la amplia distribución geográfica de sus patógenos y vectores, así como a la interacción compleja entre los humanos, los animales reservorios y las garrapatas que actúan como vectores. Ehrlichia chaffeensis, la especie de Ehrlichia más común que infecta a los humanos, es responsable de la ehrlichiosis mononuclear humana. Esta bacteria se encuentra predominantemente en el centro-sur de los Estados Unidos, especialmente en estados como Arkansas, Missouri y Oklahoma, aunque también se han reportado casos en otras regiones, incluyendo Ciudad de México y Japón. Esto sugiere que E. chaffeensis es mucho más ubicua de lo que se reconocía anteriormente. Por otro lado, Ehrlichia ewingii causa una forma similar de enfermedad denominada ehrlichiosis granulocítica humana, que afecta los glóbulos blancos. Representa aproximadamente el 10% de los casos de ehrlichiosis en los Estados Unidos, y la mayoría de los casos en el país se registran en el Medio Oeste y el Sureste.
En cuanto a la anaplasmosis humana, esta es causada por la bacteria Anaplasma phagocytophilum, y la mayoría de los casos en los Estados Unidos se reportan en regiones como Nueva Inglaterra, Nueva York, Minnesota y Wisconsin. De manera similar a la ehrlichiosis, la anaplasmosis también está comenzando a aparecer con mayor frecuencia en Asia (en países como Corea del Sur, Mongolia y China, donde se ha identificado una nueva especie, Anaplasma capra) y en Europa del Norte.
En América del Norte, los principales vectores de estas enfermedades son garrapatas de distintas especies. El principal vector para Ehrlichia chaffeensis y Ehrlichia ewingii es la garrapata Amblyomma americanus, también conocida como la garrapata de estrella solitaria. Mientras tanto, la garrapata de patas negras (Ixodes scapularis), que es famosa por su papel en la transmisión de la enfermedad de Lyme (Borrelia burgdorferi) y la babesiosis (Babesia microti), también actúa como vector de Anaplasma phagocytophilum. Esta especie de garrapata está ampliamente distribuida por la región noreste y los Grandes Lagos, y también se considera un posible vector de Ehrlichia muris eauclairensis. Además, la garrapata Ixodes pacificus, que habita la costa del Pacífico de los Estados Unidos, también transmite Anaplasma phagocytophilum.
Los vectores responsables de los casos de ehrlichiosis y anaplasmosis en Europa y Asia son especies del género Ixodes, como Ixodes ricinus en Europa y Ixodes persulcatus en Asia. En cuanto a los reservorios principales de estas enfermedades, se sabe que el ciervo de cola blanca (Odocoileus virginianus) es el reservorio principal para la ehrlichiosis mononuclear humana, mientras que el ratón de pies blancos (Peromyscus leucopus) es el principal reservorio de la anaplasmosis granulocítica humana. Otros mamíferos también están involucrados en la transmisión de estas enfermedades.
Además de la transmisión natural por garrapatas, existen informes de transmisión de anaplasmosis a través de transfusiones de sangre, lo que sugiere que la vía parenteral puede ser un riesgo adicional de transmisión. La presencia continua de estas enfermedades en los Estados Unidos se debe a factores ecológicos, como la alta densidad de garrapatas en ciertas regiones, la prevalencia de los animales reservorios y el cambio climático, que favorece la expansión de estos vectores y patógenos a nuevas áreas geográficas.
La incidencia de enfermedades como la ehrlichiosis mononuclear humana, la ehrlichiosis granulocítica humana y, en particular, la anaplasmosis ha mostrado un aumento significativo en los últimos años. Este aumento de casos puede explicarse por varios factores, entre ellos, el incremento en las poblaciones de garrapatas, que son los principales vectores de estas enfermedades, y una mayor conciencia y capacidad para diagnosticar estas infecciones, lo que lleva a una mejor notificación de los casos. En muchas jurisdicciones, las infecciones causadas por Ehrlichia y Anaplasma son enfermedades notificables a los departamentos de salud locales y estatales, lo que contribuye también al incremento en la cantidad de casos reportados.
En cuanto a la población afectada, los casos de ehrlichiosis y anaplasmosis humanas se dan con mayor frecuencia en hombres blancos no hispánicos mayores de 50 años. Esta tendencia podría estar relacionada con factores de exposición ambiental, como actividades al aire libre, que son más comunes en esta franja etaria. Además, la prevalencia de estas enfermedades en individuos de mediana edad podría reflejar una mayor interacción con áreas donde las garrapatas están presentes, como bosques o zonas rurales, lugares propensos a la alta densidad de vectores.
Es importante destacar que las infecciones por Ehrlichia y Anaplasma pueden ser causadas por más de un agente patógeno en la misma región geográfica. Este fenómeno puede complicar la identificación precisa del agente causante, lo que lleva a que algunos casos sean reportados como “ehrlichiosis/anaplasmosis humana indeterminada” cuando no se puede identificar la especie específica responsable de la infección. La coexistencia de diferentes especies patógenas en una misma área puede llevar a dificultades en la vigilancia epidemiológica, ya que los síntomas de ambas infecciones pueden ser similares, y la identificación microbiológica es crucial para determinar el tratamiento adecuado.
Una posible explicación para el aumento de los casos podría ser el aumento concomitante en las poblaciones de garrapatas. Factores como el cambio climático y la expansión de los hábitats de estos vectores han favorecido su proliferación, lo que a su vez ha facilitado la transmisión de estos patógenos a la población humana. De hecho, los brotes de ehrlichiosis y anaplasmosis suelen estar correlacionados con picos en la densidad de garrapatas, que pueden ser más numerosos en determinadas estaciones del año, como la primavera y el verano, cuando las garrapatas están más activas.
En términos de gravedad, la tasa de letalidad para la infección por Ehrlichia chaffeensis es relativamente baja, con un 1% de los casos resultando en muerte, mientras que la tasa de letalidad en los casos de anaplasmosis humana es aún menor, aproximadamente del 0,3%. Esto sugiere que, aunque estas infecciones pueden ser graves y requerir tratamiento oportuno, las tasas de mortalidad son comparativamente bajas en general. En el caso de Ehrlichia ewingii, que causa una forma de ehrlichiosis granulocítica humana, los pacientes infectados generalmente son inmunocompetentes, y no se han reportado muertes asociadas a esta especie, ni tampoco se ha observado mortalidad por Ehrlichia muris eauclairensis.
Aunque las tasas de letalidad son bajas, existen casos raros de transmisión de Ehrlichia chaffeensis y Anaplasma phagocytophilum a través de trasplantes de órganos sólidos. En estos casos, las infecciones suelen ocurrir en pacientes que han recibido un trasplante de órganos, como el corazón o los pulmones, y se observan principalmente en hombres de mediana edad. A pesar de que la transmisión por trasplante es poco frecuente, existen informes de que algunos pacientes han desarrollado infecciones graves en estos contextos, lo que pone de manifiesto la necesidad de investigar y controlar los posibles riesgos de transmisión de enfermedades infecciosas durante los procedimientos de trasplante. En una serie de 13 casos reportados de anaplasmosis asociada a trasplante, se produjeron dos muertes, lo que resalta la seriedad de la infección cuando ocurre en individuos inmunocomprometidos.
En la actualidad, no existe un protocolo de cribado rutinario preoperatorio para detectar estas infecciones en candidatos a trasplante, lo que representa un desafío en términos de prevención de infecciones postoperatorias. Esto podría estar contribuyendo a la aparición de casos de infección post-trasplante que son difíciles de identificar y manejar, especialmente en pacientes que ya presentan un sistema inmunológico comprometido.
Manifestaciones clínicas
La enfermedad clínica causada por la ehrlichiosis mononuclear humana puede variar desde formas leves hasta casos potencialmente mortales. En general, el curso de la enfermedad comienza tras un periodo de incubación de entre una y dos semanas, durante el cual los pacientes experimentan un pródromo caracterizado por malestar general, mialgias, escalofríos y náuseas. A continuación, suelen aparecer fiebre alta y cefalea, síntomas que son típicos de esta infección. Además, en algunos casos puede aparecer una erupción cutánea pleomórfica, cuya presentación es variable y no siempre está presente. La gravedad de la enfermedad tiende a ser mayor en pacientes inmunosuprimidos, incluidos aquellos que han recibido trasplantes de órganos, así como en personas mayores, debido a la menor capacidad de su sistema inmunológico para controlar la infección.
Aunque la mayoría de los casos de ehrlichiosis mononuclear humana son moderados o autolimitados, existen secuelas graves y raras que pueden comprometer la vida del paciente. Entre las complicaciones más serias se encuentran el fallo respiratorio agudo y el síndrome de dificultad respiratoria aguda (SDRA), condiciones que pueden poner en riesgo inmediato la vida del paciente debido a la insuficiencia respiratoria. También pueden surgir complicaciones neurológicas, siendo las más comunes la meningoencefalitis y la meningitis aséptica, que se caracterizan por inflamación tanto en las meninges como en el cerebro. En algunos casos, la infección puede afectar otros órganos, provocando enfermedad renal aguda, la cual puede confundirse clínicamente con la púrpura trombocitopénica trombótica debido a las características similares en los análisis de sangre. Otra complicación grave es el síndrome hemofagocítico, un trastorno inmunológico en el que el sistema inmune comienza a atacar y destruir las propias células del cuerpo, lo que puede llevar a una falla multiorgánica.
Las manifestaciones clínicas de la ehrlichiosis granulocítica humana y la anaplasmosis, aunque son causadas por patógenos diferentes, son similares a las de la ehrlichiosis mononuclear humana. Ambas enfermedades se presentan con síntomas como fiebre, malestar general, mialgias, y cefalea, lo que puede dificultar el diagnóstico diferencial sin una identificación microbiológica precisa. Sin embargo, a diferencia de la ehrlichiosis mononuclear humana, la erupción cutánea es poco frecuente en la ehrlichiosis granulocítica humana y la anaplasmosis. Cuando la erupción está presente, es necesario considerar la posibilidad de una coinfección con otras enfermedades transmitidas por garrapatas o una alternativa diagnóstica, ya que la aparición de erupción en estas infecciones no es común.
En algunos pacientes, la infección puede ser asintomática, lo que complica aún más la detección y el diagnóstico temprano de la enfermedad. Por otro lado, en aquellos pacientes con una forma más grave de la enfermedad, el malestar general y la fiebre persistente pueden prolongarse durante años, lo que genera un impacto significativo en la calidad de vida del paciente, y la infección puede no resolverse completamente a pesar del tratamiento. En este sentido, se han reportado casos en los que los síntomas de fiebre y malestar general persisten durante dos o más años, incluso después de que la infección haya sido tratada, lo que pone en evidencia la capacidad de estos patógenos para inducir una respuesta inmune crónica o disfuncional.
Además de las complicaciones mencionadas, la anaplasmosis se asocia con varios trastornos hematológicos, como la hiponatremia (bajos niveles de sodio en sangre), leucopenia (reducción en el número de leucocitos o glóbulos blancos) y trombocitopenia (disminución de las plaquetas), que pueden ser indicativos de la severidad de la infección. Otra complicación rara pero grave que se ha reportado es el infarto cerebral agudo, una condición que resulta de la interrupción del flujo sanguíneo al cerebro y que puede ser fatal o dejar secuelas neurológicas permanentes. La anaplasmosis también puede presentarse en coinfección con otras enfermedades transmitidas por garrapatas, como la enfermedad de Lyme o la babesiosis. En estos casos, las manifestaciones clínicas, que incluyen fiebre y citopeñas (bajas concentraciones de células sanguíneas), son más graves cuando el paciente está infectado por Anaplasma phagocytophilum (causante de la anaplasmosis) que cuando está infectado únicamente por Borrelia burgdorferi (causante de la enfermedad de Lyme), lo que resalta la mayor agresividad de la anaplasmosis.
Además, se ha identificado un espiroqueta, Borrelia miyamotoi, que puede mimetizar los síntomas de la anaplasmosis en su presentación clínica. Esto complica aún más el diagnóstico, ya que Borrelia miyamotoi produce manifestaciones similares, lo que hace necesario realizar pruebas microbiológicas detalladas para diferenciar entre las diversas infecciones transmitidas por garrapatas.
Exámenes diagnósticos
El diagnóstico de la ehrlichiosis humana puede realizarse a través de una combinación de la historia clínica del paciente, que incluye la exposición a garrapatas, y la presentación clínica característica de la enfermedad. La sospecha clínica se ve reforzada por los síntomas típicos, como fiebre, malestar general y dolor muscular, junto con los hallazgos laboratoriales que incluyen alteraciones hematológicas frecuentes. Entre los cambios más comunes en los análisis de sangre se encuentran la leucopenia (disminución en el número total de leucocitos), la linfopenia absoluta (baja cantidad de linfocitos), la trombocitopenia (baja cantidad de plaquetas) y la transaminitis (aumento de las enzimas hepáticas, lo que indica daño hepático). Estos hallazgos son comunes tanto en la ehrlichiosis mononuclear humana como en la ehrlichiosis granulocítica humana.
En particular, la trombocitopenia se observa con mayor frecuencia que la leucopenia en los casos de ehrlichiosis granulocítica humana. Este patrón hematológico, en el que las plaquetas son más afectadas que los glóbulos blancos, es uno de los elementos diferenciadores en la evaluación de la enfermedad. Además, se ha reportado hiponatremia, que es la disminución de los niveles de sodio en sangre, que generalmente ocurre debido a la deshidratación por pérdida de volumen, lo que refuerza la necesidad de una hidratación adecuada en el manejo de la enfermedad.
Uno de los métodos diagnósticos más tradicionales es la examinación de la sangre periférica utilizando una tinción de Giemsa. Esta técnica puede revelar la presencia de vacuolas intraleucocíticas características, conocidas como morulae, que son acumulaciones de bacterias dentro de los glóbulos blancos. Aunque este hallazgo es indicativo de la infección, se observa solo en un porcentaje de pacientes, alcanzando hasta un 20% de los casos, lo que significa que no siempre es un hallazgo diagnóstico definitivo, pero sí es sugerente de la enfermedad.
Además de la tinción de Giemsa, existen pruebas serológicas que pueden ayudar a confirmar el diagnóstico. Una de ellas es la prueba de anticuerpos fluorescentes indirectos. Esta prueba requiere muestras de suero tanto en la fase aguda como en la fase de convalecencia de la enfermedad. La presencia de anticuerpos en estas dos fases permite confirmar que el paciente ha estado expuesto al patógeno y ha desarrollado una respuesta inmunológica a la infección.
Sin embargo, el diagnóstico temprano de la ehrlichiosis humana se puede hacer de manera más efectiva mediante el uso de la reacción en cadena de la polimerasa (PCR), que es una herramienta diagnóstica molecular muy útil. La PCR permite detectar el ADN del patógeno en muestras de sangre, lo que facilita la identificación de la infección en las primeras etapas de la enfermedad, incluso antes de que el cuerpo haya generado suficientes anticuerpos para detectarse en las pruebas serológicas. Esta prueba es especialmente sensible en la primera semana de la enfermedad, lo que la convierte en una herramienta clave para realizar un diagnóstico precoz. La PCR también puede servir como una prueba confirmatoria en pacientes con presentación clínica sugestiva y hallazgos de laboratorio compatibles.
El uso de la PCR en la fase temprana de la enfermedad es crítico porque en estos momentos los síntomas son menos específicos y pueden ser fácilmente confundidos con otras infecciones bacterianas o virales. Al detectar el material genético del patógeno, la PCR ofrece una certeza diagnóstica más rápida y precisa, lo que facilita la implementación de un tratamiento adecuado sin la espera de resultados serológicos, que pueden tardar más tiempo en ser positivos.
En resumen, el diagnóstico de la ehrlichiosis humana se basa en una evaluación integral que incluye una historia clínica detallada, especialmente en relación con la exposición a garrapatas, una presentación clínica característica y varios hallazgos de laboratorio. Los métodos diagnósticos incluyen la tinción de Giemsa para observar morulae en los glóbulos blancos, pruebas serológicas como la prueba de anticuerpos fluorescentes indirectos, y técnicas moleculares como la PCR, que es particularmente útil en las primeras etapas de la enfermedad. La combinación de estos enfoques permite un diagnóstico preciso y oportuno, lo que es fundamental para el manejo adecuado de la enfermedad y la reducción de complicaciones.
Tratamiento y prevención
El tratamiento para la ehrlichiosis humana y la anaplasmosis se basa principalmente en el uso de doxiciclina, un antibiótico de amplio espectro eficaz contra las bacterias intracelulares causantes de estas enfermedades. La dosis recomendada es de 100 mg dos veces al día, ya sea por vía oral o intravenosa, durante un período de 10 a 14 días, o hasta que el paciente haya experimentado tres días consecutivos de defervescencia (disminución sostenida de la fiebre). La doxiciclina actúa inhibiendo la síntesis de proteínas bacterianas, lo que interfiere con la capacidad de los patógenos para replicarse, contribuyendo así a su erradicación. En general, la doxiciclina ha demostrado ser eficaz y bien tolerada en el tratamiento de ambas enfermedades, por lo que es considerada el tratamiento de primera línea.
Sin embargo, en mujeres embarazadas, la rifampicina se considera una alternativa, debido a que la doxiciclina no es recomendada en este grupo debido a sus posibles efectos adversos sobre el feto. La rifampicina, un antibiótico que también inhibe la síntesis de ARN bacteriano, es una opción eficaz aunque menos preferida que la doxiciclina, especialmente durante el primer trimestre del embarazo. Es importante destacar que el tratamiento antibiótico no debe ser retrasado mientras se esperan los resultados confirmatorios de las pruebas serológicas, especialmente cuando la sospecha clínica es alta. El retraso en el tratamiento puede resultar en un empeoramiento de la condición del paciente, por lo que iniciar el tratamiento lo antes posible es crucial para prevenir complicaciones graves.
Si después de 48 horas de iniciar el tratamiento con doxiciclina el paciente no presenta mejoría clínica significativa, especialmente la resolución de la fiebre, es posible que sea necesario reconsiderar el diagnóstico. La falta de defervescencia dentro de este plazo sugiere que podría haber un diagnóstico alternativo que explique los síntomas persistentes. Este tipo de situación implica que la infección por Ehrlichia o Anaplasma no está siendo controlada adecuadamente por el antibiótico administrado, y podrían estar involucrados otros factores o patógenos. En estos casos, se debe realizar una reevaluación exhaustiva para descartar infecciones concurrentes o diagnósticos alternativos.
Aunque la mayoría de los pacientes responden bien al tratamiento y se recuperan sin mayores complicaciones, algunos pueden continuar experimentando síntomas como cefalea, debilidad y malestar general durante semanas, incluso después de haber recibido un tratamiento adecuado. Estos síntomas residuales son relativamente comunes y pueden estar relacionados con la inflamación prolongada o la respuesta inmune del cuerpo tras la infección, lo que indica que la recuperación completa puede ser un proceso gradual.
En términos de prevención, el control de las garrapatas es la medida fundamental, ya que estas son los vectores principales de las enfermedades. La implementación de estrategias para evitar las picaduras de garrapatas, tales como el uso de repelentes, el uso de ropa protectora al estar en áreas de alto riesgo y la revisión regular del cuerpo en busca de garrapatas, son prácticas cruciales para reducir la incidencia de ehrlichiosis y anaplasmosis. El control ambiental de las garrapatas, como el manejo de la vegetación y el tratamiento de áreas donde estas se encuentran, también juega un papel importante en la prevención.
Dado el aumento en la prevalencia y el reconocimiento de estas enfermedades, es necesario establecer protocolos de cribado para trasplantes de órganos sólidos y transfusiones de sangre para prevenir infecciones postoperatorias. Los pacientes inmunocomprometidos, como aquellos que han recibido un trasplante, tienen un mayor riesgo de desarrollar infecciones graves debido a su sistema inmunológico debilitado. La implementación de medidas de cribado para detectar posibles infecciones por Ehrlichia y Anaplasma en los donantes de órganos y en la sangre destinada a transfusiones podría ayudar a prevenir la transmisión de estas infecciones en los contextos clínicos mencionados. En los trasplantes de órganos, en particular, la exposición a estas infecciones puede comprometer la salud del receptor, lo que subraya la importancia de estrategias preventivas y diagnósticas más rigurosas en la práctica clínica.

Fuente y lecturas recomendadas:
Centers for Disease Control and Prevention (CDC). Ehrlichiosis: epidemiology and statistics. https://www.cdc.gov/ehrlichiosis/stats/index.html
Centers for Disease Control and Prevention (CDC). Anaplasmosis: epidemiology and statistics. https://www.cdc.gov/anaplasmosis/stats/index.html